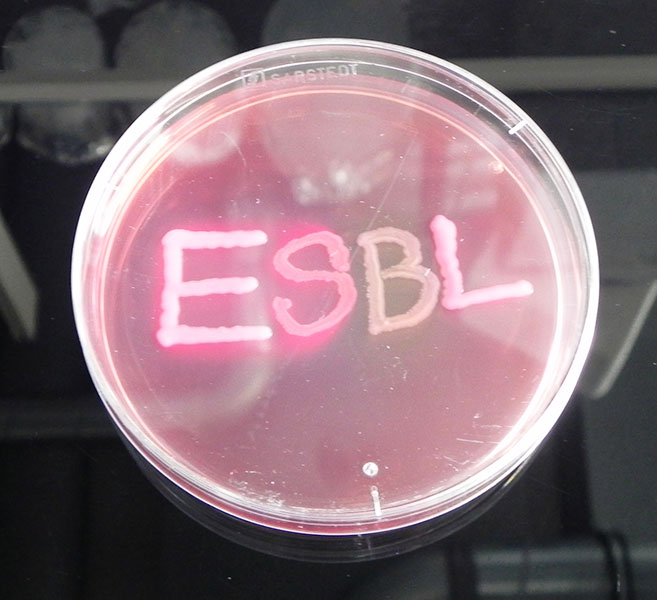
Multiresistente Keime in einer typischen Laborschale. Im Labor werden die Bakterien auf speziellen Nährböden gezüchtet. Aber auch in unserer Umwelt wachsen multiresistente Keime. Foto: Justus-Liebig Universität Gießen

Krankenhauskeime finden sich nicht nur im Krankenhaus. Eine aktuelle Studie aus Deutschland zeigt, dass multiresistente Keime auch in der Landwirtschaft weit verbreitet sind. Ein Forschungsverbund untersucht, ob diese Risiken für den Menschen bergen.

Bakterien sind überall. Sie haben lange vor dem ersten Menschen die Erde besiedelt. Ohne sie könnten wir nicht überleben. Oft bemerken wir sie aber erst, wenn Sie uns schaden. Denn manchmal rufen sie ernste Erkrankungen hervor. Dann können wir dank Penicillin und anderer Antibiotika die Keime bekämpfen. Doch immer häufiger bleiben diese Antibiotika wirkungslos. Der Grund ist, dass Bakterien eigene Abwehrmechanismen haben. Antibiotika werden für die Medizin entwickelt und dort auch bei Mensch und Tier eingesetzt. Doch sie werden auch von vielen Organismen gebildet, um sich gegen Bakterien zu schützen. Deshalb können Bakterien in der Natur auch schon Resistenzen gegen diese Antibiotika entwickeln, ganz ohne menschliches Zutun. Manche dieser Informationen können sie sehr schnell untereinander austauschen und so mehrere Resistenzen anhäufen: Sie werden multiresistent. Entzündungen, die durch multiresistente Keime verursacht werden, können für den Menschen gefährlich werden. Allein in Europa wird die Zahl der Todesfälle durch multiresistente Erreger auf jährlich 10.000 bis 15.000 geschätzt.
Neue Bedrohung durch vielfältigen Austausch?
Multiresistente Keime in einer typischen Laborschale. Im Labor werden die Bakterien auf speziellen Nährböden gezüchtet. Aber auch in unserer Umwelt wachsen multiresistente Keime.
Justus-Liebig Universität Gießen
Dabei kann jeder Mensch Träger multiresistenter Keime sein. Nur, gesunde Personen bemerken das oftmals gar nicht, denn die resistenten Keime mischen sich unter die normale Keimflora. Doch nicht nur Menschen können multiresistente Keime tragen und weitergeben. Auch Tiere – und hier besonders landwirtschaftlich genutzte Tiere – können multiresistente Keime tragen. Das erscheint zunächst nicht weiter bedeutsam. Denn Bakterien sind häufig auf ihre Wirte spezialisiert. Erreger, mit denen sich Tiere anstecken, sind meist für Menschen ungefährlich. Aber es gibt auch Bakterien, die ein weites Wirtsspektrum haben und auch den Menschen einschließen.
Deshalb können tierische Erreger zuweilen für Menschen gefährlich werden. Fachleute sprechen von Zoonosen.
Durch verschiedene Übertragungswege kann ein solcher Erreger die Barriere zwischen Tier und Mensch überwinden. Ein Beispiel hierfür sind Darmbakterien, auch Enterobakterien genannt. Sie können durch Tierkontakt, bei der Schlachtung oder über Tierkot, den Stallmist, der als Dünger eingesetzt wird, in die Umgebung und in die Lebensmittelkette und letztendlich zum Menschen gelangen. Ein Problem entsteht, wenn diese Enterobakterien sich vor therapeutisch besonders wichtigen Antibiotika schützen können, das heißt, wenn sie den Bauplan für bestimmte Enzyme haben, die sogenannten Beta- Laktamasen oder kurz ESBL. Denn ESBL spalten Bestandteile bestimmter Antibiotika und lassen sie so unwirksam werden.
Der vom Bundesforschungsministerium geförderte Forschungsverbund RESET untersucht unter anderem, wie häufig und wo Enterobakterien, die ESBL herstellen können, in der Landwirtschaft gefunden werden. RESET steht für „ESBL and (fluoro)quinolone RESistance in EnTerobacteriaceae“. Hier arbeiten Forschende aus den unterschiedlichsten Bereichen zusammen. „Diese enge kooperative Zusammenarbeit verschiedener Wissenschaftsdisziplinen, wie der Tier-und Humanmedizin, aber auch der Naturwissenschaften und der Epidemiologie in Universitäten und der Bundesressortforschung, ist im internationalen Vergleich einmalig“, sagt Professor Dr. Lothar Kreienbrock. Er führt das Institut für Biometrie, Epidemiologie und Informationsverarbeitung an der tierärztlichen Hochschule in Hannover und leitet das Projekt RESET.
Unter Zoonosen verstehen Wissenschaftlerinnen und Wissenschaftler Krankheiten, die zwischen Tieren und Menschen übertragen werden können. Immer wieder tauchen neue Erreger, beispielsweise Viren, auf, die neben Tieren auch Menschen infizieren können. Ein Beispiel ist die Vogelgrippe. Auch die Infektionskrankheit Ebola ist eine Zoonose. Steht das humane Immunsystem der neuen Herausforderung machtlos gegenüber, können Zoonosen sich rasch ausbreiten. Experten schätzen, dass mehr als die Hälfte aller bekannten Erreger, die Infektionen beim Menschen auslösen, zwischen Tier und Mensch übertragen werden. Das Bundeskabinett hat schon 2006 eine Forschungsvereinbarung zu Krankheitserregern beschlossen, die von Tieren auf Menschen übertragbar sind. Beteiligt sind die Bundesministerien für Ernährung und Landwirtschaft (BMEL), für Bildung und Forschung (BMBF) und für Gesundheit (BMG). Durch verbesserte Zusammenarbeit von Veterinärmedizin und Humanmedizin soll die Übertragung von Erregern vom Tier auf den Menschen gemeinsam erforscht werden. Das BMBF fördert seit Juli 2007 13 interdisziplinäre Forschungsverbünde zu zoonotischen Infektionskrankheiten. 2008 wurde die Nationale Forschungsplattform für Zoonosen eingerichtet. Sie wird ressortübergreifend von den drei genannten Ministerien getragen.
Multiresistente Keime im Tierstall
Die ersten Studienergebnisse in landwirtschaftlichen Betrieben in ganz Deutschland haben viel Aufmerksamkeit erlangt: In jedem von insgesamt 34 untersuchten Betrieben der Hähnchenmast wurden ESBL-bildende Enterobakterien gefunden. Bei Schweine- und Rindermastbetrieben waren es nur geringfügig weniger, aber auch hier konnten bei fast jedem Betrieb ESBL-bildende Darmbakterien nachgewiesen werden (85 Prozent bei Schweinen und 80 Prozent bei Rindern). Selbst in Betrieben, in denen die Tiere nur mit geringen Antibiotikamengen oder gar nicht behandelt wurden, ließen sich resistente Keime finden.

Aktuelle Ergebnisse zeigen: Auch Tiere – und hier besonders landwirtschaftlich genutzte Tiere – können multiresistente Keime tragen.
Shutterstock: Ints Vikmanis
Dabei zeigte sich, dass die multiresistenten Keime nicht nur in den Tieren selbst zu finden sind, sondern dass sie sich auch im Tierstall und in der Umgebung nachweisen lassen.
In speziellen Untersuchungen wurde daher präparierte Gülle experimentell als Dünger auf die Felder aufgetragen. Danach fanden sich in den Böden und den Gemüsepflanzen sowohl Rückstände von Antibiotika als auch multiresistente Enterobakterien.
„Noch wissen wir nicht, ob durch die Verbreitung der multiresistenten Bakterien in der Landwirtschaft tatsächlich ein Gesundheitsrisiko für die Verbraucher entsteht“, sagt Kreienbrock. Der Forschungsverbund fand bei menschlichen Enterobakterien auch ESBL bildende Stämme. Die Wissenschaftlerinnen und Wissenschaftler gehen davon aus, dass dies derzeit bei ungefähr sechs Prozent der Allgemeinbevölkerung der Fall ist. Die gefundenen Keime stimmen allerdings nur in Teilen mit denen aus der Landwirtschaft überein, sodass die Größenordnung der Übertragung von Tiere auf Menschen, aber auch von Menschen auf Tiere derzeit noch nicht endgültig bewertet werden kann.
„Unsere Ergebnisse zeigen aber auch, dass es bereits jetzt sinnvoll ist, Maßnahmen zu ergreifen, die zum Beispiel die hygienische Situation verbessern, um Resistenzentstehung und -verbreitung zu vermindern“, so Kreienbrock.

Noch ist unklar, ob durch die Verbreitung multiresistenter Bakterien in der Landwirtschaft tatsächlich ein Gesundheitsrisiko für die Verbraucherinnen und Verbraucher entsteht.
fotolia: Igrik
Schnellere und einheitliche Nachweismethode
Ein erster Schritt ist schon getan: International hat der Forschungsverbund dazu beigetragen, dass die Methode zum Nachweis und zur Charakterisierung von ESBL-Resistenzen vereinheitlich wurde. Die vom RESET-Verbund etablierte Methode wurde vom gemeinschaftlichen Referenzlabor für Antibiotikaresistenz geprüft und wird nun für die in der gesamten EU verpflichtend durchzuführenden Untersuchungen empfohlen. Geholfen hat dabei die internationale Vernetzung der beteiligten Wissenschaftlerinnen und Wissenschaftler. Auch die gemeinsam geschaffenen Datenbanken erleichtern den Wissensaustausch und die Charakterisierung resistenter Bakterienstämme. „Wir haben nunmehr die Grundlage geschaffen, zukünftig im Detail zu untersuchen, welche Gefahr von diesen multiresistenten Keimen ausgeht und wie hoch das Risiko für den Menschen ist“, sagt der Verbundleiter.
DART steht für „Deutsche Antibiotika-Resistenzstrategie“. Es ist eine gemeinsame Strategie des Bundesministeriums für Gesundheit (BMG), des Bundesministeriums für Ernährung und Landwirtschaft (BMEL) und des Bundesministeriums für Bildung und Forschung (BMBF). Eine erste Strategie wurde bereits in 2008 verabschiedet und in den folgenden Jahren umgesetzt. Das Ziel: Entstehung und Ausbreitung von Antibiotika-Resistenzen zu verhindern. Die DART 2020 setzt diese Anstrengungen nun in mehreren Arbeitsgebieten verstärkt fort. Das BMBF fördert entsprechende Forschungsbereiche in der Human-und Veterinärmedizin und bringt interdisziplinäre Forschungsvorhaben voran, von der Grundlagenforschung zur Resistenzentstehung und -verbreitung bis hin zur Entwicklung neuer Diagnostika und Arzneimittel. Eine Broschüre zu DART2020 finden Sie hier.
Ansprechpartner:
Professor Dr. Lothar Kreienbrock
Institut für Biometrie, Epidemiologie und Informationsverarbeitung
Tierärztliche Hochschule Hannover
Bünteweg 2
30559 Hannover
0511 953-7950
0511 953-7974
lothar.kreienbrock@tiho-hannover.de
http://reset-verbund.de